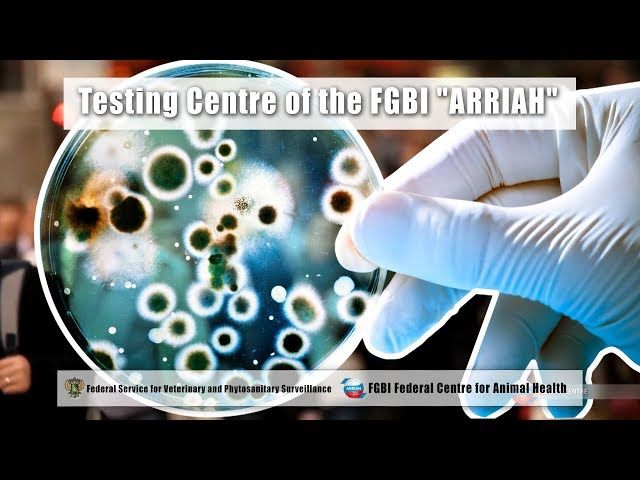

Image source:
Image source:
Federal Center for Animal Health (FGBI "ARRIAH" Rosselkhoznadzor)
Location: The organization is located in Russia and plays a pivotal role in the animal health sector.
Important Events: Experts from the Federal Center for Animal Health have been actively participating in the preparation and coordination of documents, not only within Russia but also involving representatives from all CIS member countries. This collaboration highlights the center's leadership in regional animal health initiatives.
Financial Indicators: While specific financial data is not provided, the involvement of the Federal Center in significant regional initiatives suggests a well-supported and funded operation capable of impacting animal health policies.
Plans: The center continues to focus on strengthening its role in the preparation and coordination of health documents, enhancing its influence and ensuring the health safety of animals within the CIS region.
Modified: 2026/07/03